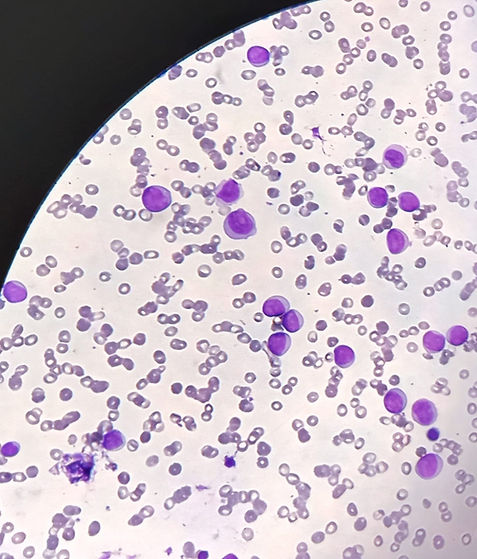
acute lymphoblastic leukemia.jpg
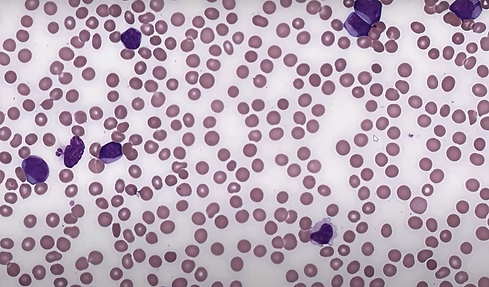
AML3.png

top of page
Acute Leukemia
Acute leukemia is defined as the proliferation of immature white blood cells that comprise more than 20% of the cells of the bone marrow or peripheral blood.

In acute lymphoblastic leukemia (ALL), the peripheral blood count can be low, normal, or high, although frequently it is high and composed of mostly blasts.
bottom of page